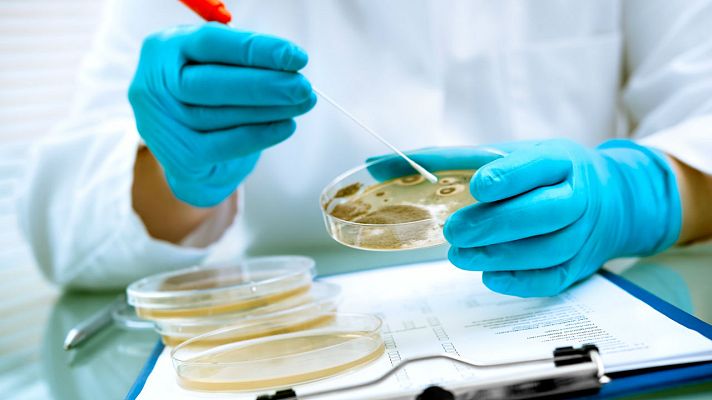
La mañana - ¿Qué comunidades están afectadas por listeriosis?

La mañana
¿Qué comunidades están afectadas por listeriosis?
La mañana - ¿Qué comunidades están afectadas por listeriosis?
Disponible hasta: 21-02-2222
21/08/2019 00:02:18